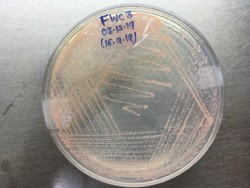
Dr. Monali Rahalkar Research Image5
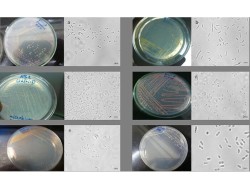
Dr. Monali Rahalkar Research Image7

Nanobioscience
Nanobioscience group was established in 2007 as a spin-off of the erstwhile ‘Metal-Microbe Interactions’ group of the Microbial Sciences Division. In an effort to seek an answer to a rather unpretentious question ‘do metal-interacting microbes synthesize nanoparticles?’ the group pioneered a new approach for the synthesis of metal-based nanomaterials, viz. ‘Materials Science and Engineering through Microbiology’. Eventually concerted efforts were made to develop a strong research program on Nanobioscience in the Institute covering an entire gamut of the subject.
Research Interest:
Our research interests range from nanomaterials syntheses & characterization to development of products, miniaturization of devices and understanding various biological phenomena; all directed to the ultimate goal of improving human health, agriculture and environment.
The group has multidisciplinary expertise in areas such as microbiology, biotechnology, pharmaceutical sciences, virology, physics and chemistry.
Google Scholar / Social Media
Name: Dr. Jyutika Rajwade
Designation: Scientist – F
Brief Background :
After completing Master’s in Industrial Microbiology, I joined MACS for doctoral studies and worked on metal-microbe interactions. After doctoral studies, I worked as a CSIR research associate in ARI and teaching research associate at Department of Biotechnology, Pune University. For the past 13 years I am working as a research scientist in the Nanobioscience group. I have worked in applications of Microbiology, Biotechnology in Nanobioscience. Working with Ph.D scholars has led to research publications in scientific journals of international repute.
Contact Details :
02025325131 (Telephone)
Educational Qualification
- B.Sc. (1989) Microbiology, Chemistry, Zoology
- M.Sc (1991) Microbiology
- Ph.D (1997) Microbiology
Research Interests
My research deals with applications of nanomaterials in various fields. Metals-based nanoparticles were explored for their antimicrobial activity for achieving control of bacterial pathogens. Effects of silver nanoparticles on bacterial biofilms was studied at the transcriptome level. For early detection of diseases in aquaculture, lateral flow assay platform was developed and validated for detection of white spot syndrome virus, Macrobrachiumrosenbergiinodavirus. For detection of Vibriosis, chromogenic immunosensor is under development. Several biomolecules are being explored as biorecognition elements in the development of diagnostics. Naturally occurring polymeric nanostructures specifically bacterial cellulose is being explored for applications in nanobiotechnology.As part of applications of nanotechnology in agriculture, the potential of nanomaterials as micronutrient delivery systems and also as carriers for protein antigens for oral vaccination in aquaculture.
List of Publications/ Patents/Varieties:
Papers published in refereed journals
- Mayattu K, Rajwade J, Ghormade V. Development of erythromycin loaded PLGA nanoparticles for improved drug efficacy and sustained release against bacterial infections and biofilm formation. MicrobPathog. 2024 Oct 23:107083. doi: 10.1016/j.micpath.2024.107083. Epub ahead of print. PMID: 39454804.
- S. Tawre, A. Padhye, S. Chakraborty, N. Kulkarni, G. Bose, S. Mittal, U. Jadhav, S. Jadhav, J.M. Rajwade, K. Pardesi, Bioactive Curcuma aromatica-stabilized silver nanoparticles embedded chitosan dressing with improved antibacterial, anti-inflammatory, and wound healing properties. Carbohydrate Polymer Technologies and Applications 8 (2024) 100570.
- Savardekar A, Fernandes E, Padhye-Pendse A, Gupta T, Pol J, Phadke M, Desai S, Jadhav S, Rajwade J, Banerjee A. Adipocytes Promote Endometrial Cancer Progression Through Activation of the SIRT1-HMMR Signaling Axis. Molecular Carcinogenesis. 2024 1002/mc.23815. Epub ahead of print. PMID: 39254492.
- Naik, A., A. A. Kale, J. M. Rajwade (2024) Sensing the future: A review on emerging technologies for assessing and monitoring bone health. Biomaterials Advances, 165, 214008, doi:10.1016/j.bioadv.2024.214008.
- MadiwalV,RajwadeJ.Silver-depositedtitaniumasaprophylactic’nanocoat’forperi-NanoscaleAdv.2024Mar7;6(8):2113-2128.
- Padhye-PendseA,UmraniR,PaknikarK,JadhavS,RajwadeJ.LifeSci.2024Jun15;347:122667.
- Deshpande,P.,Wankar,S.,Gumathannavar,R.,Kulkarni,S.,Jadhav,Y.,Patil,Y.,RajwadeJ.Kulkarni,(2024).Harnessingphotocurrentenhancementinsilver- bacterialcellulosenanocompositeforultra-sensitiveHg2+electrochemicaldetection.Nanocomposites,10(1),227–240.
- Madiwal,B.Khairnar,J.M.Rajwade(2024)Enhancedantibacterialactivityandsuperiorbiocompatibilityofcobalt-depositedtitaniumdiscsforpossibleuseinimplantdentistry,iScience,27(2),108827,doi:10.1016/j.isci.2024.108827.
- D.Khairnar,A.Jha,J.M.Rajwade(2023)Rationallydesignedcyclicpeptidesandnanomaterialsas‘next-generation’anti-amyloidtherapeutics.JMaterSci.58,9834– 9860.doi:10.1007/s10853-023-08654-6
- Deshpande,S.Wankar,S.Mahajan,Y.Patil,J.Rajwade,A.Kulkarni(2023)BacterialCellulose:NaturalBiomaterialforMedicalandEnvironmentalApplications,JournalofNaturalFibers,20:2,2218623
- D.Khairnar,A.Padhye,V.Madiwal,A.Jha,S.H.Jadhav,J.M.Rajwade.(2023)Cyclicβ-hairpinpeptideloadedPLGA nanoparticles:apotentialanti-amyloidtherapeutic.Materials Today Communications35:106322.doi.org/10.1016/j.mtcomm.2023.106322
- Kheur,S.;Kheur,M.;Madiwal,V.;Sandhu,R.;Lakha,T.;Rajwade,J.;Eyüboğlu,T.F.;Özcan,M.InVitroEvaluationofPhotofunctionalizedImplantSurfacesinaHighGlucoseMicroenvironmentSimulatingDiabetics.J.Funct.Biomater.2023,14,130.https://doi.org/10.3390/jfb14030130
- Kumar,S.S.,Jamalpure,S.,Ahmed,A.N.,Taju,G.,Vimal,S.,Majeed,S.A.,Suryakodi,S.,Rahamathulla,S.,Paknikar,K.M.,Rajwade,J.M.,&Hameed,A.(2022).AnIndigenous,Field-Deployable,LateralFlowImmunochromatographicAssayRapidlyDetectsInfectiousMyonecrosisinShrimp,Litopenaeusvannamei.MarineBiotechnology(NewYork,N.Y.),24(6):1110-1124.Doi:10.1007/s10126-022-10172-6.
- DamleA.,SundaresanR.,RajwadeJ.M.,SrivastavaP.,NaikA.2022.Aconcisereviewonimplicationsofsilvernanoparticlesinbonetissueengineering.BiomaterialsAdvances.141,213099
Book Chapters Published
- Rajwade, J. M., Kawle, K., Kulkarni, S., Kowshik, M., (2023). Wound Treatment Using Nanomaterials. Nanobiomaterials: Perspectives for Medical Applications in the Diagnosis and Treatment of Diseases, 145, 207-235.
- Introduction to Finfish Microbiome and Its Importance. (2023) Jyutika M. Rajwade, Snehal S. Kulkarni, Janhavi Vanjari in Microbiome of Finfish and Shellfish. Arvind Diwan, Sanjay N. Harke, Archana Panche (Eds). https://doi.org/10.1007/978-981-99-0852-3. Springer Singapore. Pages 3-33
- Rajwade J. M., “An overview of myconanoparticles applications in veterinary medicine” in Fungal Cell Factories for Sustainable Nanomaterials Production and Agricultural Applications. Kamel Abd-Elsalam (Ed). Elsevier. 2023. pp. 657-692. dorg/10.1016/B978-0-323-99922-9.00019-2
- Rajwade, J. M., Oak, M. D., &Paknikar, K. M. (2024). Copper-based nanofungicides: The next generation of novel agrochemicals. InNanofungicidesKamel Abd-Elsalam (Ed). (pp. 141-168). https://doi.org/0.1016/B978-0-323-95305-4.00008-X
- J. Rajwade, A. Padhye,S. S. Kulkarni, (2024) Two-Dimensional (2D) Materials for Bio-sensing Applications. In.Two-dimensional Hybrid Composites Synthesis, Properties and Applications. eBook. N. Talreja, D. Chauhan, M. Ashfaq (Eds). https://doi.org/10.1007/978-981-99-8010-9. Springer Singapore. Pp 227-258
- Rajwade J. M., Chikte R. G., N. Singh., Paknikar K. M. “Copper-based nanostructures: Antimicrobial properties against agri-food pathogens” in Copper Nanostructures: Next-Generation of Agrochemicals for Sustainable Agroecosystems. Kamel Abd-Elsalam (Ed). Elsevier. 2022. pp. 477-503. doi.org/10.1016/B978-0-12-823833-2.00031-3
Indian patents granted/filed
- A method for rapid isolation and purification of DNA.(No. 43488) June 2023. Inventors: M. K. Chaudhari, J. M. Rajwade, K. M. Paknikar
- Immunoassay,peptide-basedagentandfield-usablekitforearlyrapiddetectionofwhitespotsyndromevirus(No.393879).March2022.Inventors:P.K.Kulabhushan,J.M.Rajwade,K.M.Paknikar
Ph.D. Awarded
- Snehal Jamalpure: Development of point of care diagnostics for detection of viral pathogens affecting shrimp and prawns; Guide: Dr. J. M. Rajwade
- Vaibhav Madiwal: Nanoscale surface modification of dental materials for preventing implant related failures. Guide: Dr. J. M. Rajwade
Other important information
Dr. Jyutika Rajwade is nominated to serve in the DST-WISE SCOPE Selection Committee for 3 years
Google Scholar / Social Media
Name: Dr. Dhananjay Bodas
Designation: Scientist – F
Brief Background :
After completing the basic education in Physics, Icompleted thedoctoral dissertation in Microelectronics and was awarded a Ph.D. from the University of Pune in 2004. Later, Imoved to France for first Postdoctoral fellowship awarded by the Defence Ministry of France. On completion of the fellowship tenure, for a brief period, I was appointed as Research Engineer in the same laboratory beforemoving to the Institute of Bioengineering and Nanotechnology, Singapore as a Research Scientist.
However, receipt of the prestigious Alexander von Humboldt foundation postdoctoral fellowship in 2006 was difficult to deny, which brought me back to main stream academic research attheInstitute of Microsystems, Germany. On my return to India, I worked for a start-up bigtecPvt. Ltd., Bangalore. However, due to keen interest in academic research Ichoseacademiaover industry and opted for the position of Associate Professor atthe Department of Instrumentation Science, University of Pune. Currently, Iam working as a Scientist at Nanobioscience group, Agharkar Research Institute, Pune India.
Contact Details :
9120 2532 5127 (Telephone)
Educational Qualification
- 2000-2004 Ph.D. in Microelectronics from the Department of Electronic Science, Savitribai Phule University of Pune, Pune
- 1997-1999 M.Sc. in Applied Physics, from The Maharaja Sayajirao University, Baroda
- 1994-1997 B.Sc. in Physics from The Maharaja Sayajirao University, Baroda
Research Interests
The main objective of my research is to improve quality of life by employing cutting edge technology for development of various biomedical micro devices.
My research has a strong interdisciplinary focus that combines theory and practice in areas of physics, electronics, applied chemistry, biology and micro-fabrication techniques (includes sophisticated instrument handling). Few topics which have been carried out with a common platform, i.e. microfluidics, high degree of creativity and high degree of competitiveness with no quality compromises are sketched.
A microfluidic device was developed which integrated magnetic separation of bacteria in microchannel to detect them optically using quantum dots. This combination reduces time for the enrichment and helps in rapid detection. The assembly uses multiple components like excitation light source, collimating optics, filter and a photodiode to detect the signal. The limit of detection with peptide as recognition element is found to be 10 CFU/mL with the assay time of ~15 min.
Significant improvements in microfluidic based cell culture will take us closer to creating biologically relevant cell environments and hopefully replace animal experimentation in near future. A step towards achieving this goal was by fabricating 3D scaffolds with embedded microchannel. This chip has a porous chamber and channels all fabricated in one easy unconventional step. A system was designed to utilize the chip as substrate for non-perfused as well as perfused cell culture.
A microreactor was designed and fabricated to synthesize highly monodisperse metal/semiconductor/polymer nanoparticles. Understanding the reaction kinetics was given importance during the synthesis process. It was found that nanoparticles can be synthesized with high degree of control using micro volumes and precise temperature.
Currently, my lab is focusing on two main disciplines of research.
- Diagnostics and
- Organ-on-chip development.
List of Publications/ Patents/Varieties:
Publications
- P Suryavanshi, D Bodas, Knockout cancer by nano-delivered immunotherapy using perfusion-aided scaffold-based tumor-on-a-chip, Nanotheranostics, 8 (3) 2024 380-400.
- P Suryavanshi, Y Kudtarkar, M Chaudhari, D Bodas, Fabricating a low-temperature synthesized graphene-cellulose acetate-sodium alginate scaffold for the generation of ovarian cancer spheroid and its drug assessment, Nanoscale Advances, 5 (18) 2023 5045-5053.
- V Kamat, P Dey, D Bodas, A Kaushik, A Boymelgreen, S Bhansali, Active microfluidic reactor-assisted controlled synthesis of nanoparticles and related potential biomedical applications, J. Mater. Chem. B, 2023 11 2023 5650-5667.
- Sathe, D Bodas, Development and characterization of a polydimethylsiloxane-cellulose acetate hybrid membrane for application in organ-on-a-chip, Materials Science & Engineering B, 291 2023 116366.
- S Pandey, P Choudhary, S Jadhav, V Gajbhiye, D Bodas, In vivo imaging of prostate tumor targeted using folic acid conjugated quantum dots, Cancer Nanotechnology, 14 (30) 2023 1-11.
- Pandey, D Bodas, Exploiting the UV excited size-dependent emission of PDMS-coated CdTe quantum dots for in vitro simultaneous multicolor imaging of HepG2 cellular organelles, Materials Advances, 4 2023 1694.
- S Pandey, D Bodas, Effect of micro-impeller geometries on mixing in a continuous flowactive microreactor, Materials Science & Engineering B 283 2022 115843.
- S Thakare, A Shaikh, D Bodas and V Gajbhiye, Application of dendrimer-based nanosensors in immunodiagnosis, Colloids and Surfaces B: Biointerfaces 209 2022 112174.
Books Edited
- Bodas D, Gajbhiye V. 2024. Microfluidics-aided technologies: Platforms for the next generation biological applications. Academic Press. Elsevier
Indian patents granted
- Patent No. 438851 14 Jul 2023 D Bodas, P Kulkarni, A Jadhav, S Jadhav, P Inde, A Chaudhari, A Deshpande, A Zingade, Astute footwear device with integrated sensors
- Patent No. 500353 17 Jan 2024 D Bodas, V Kulkarni, K Paknikar, 3D porous scaffolds for cell culture and tissue engineering
- Patent No. 508723 08 Feb 2024 D Bodas, K Paknikar, Microchip based portable real-time polymerase chain reactor
- Y Karpe, V Gajbhiye, D Bodas and P Dhakephalkar, Nucleic acid-based test kit to detect viral RNA, DNA, other biomolecules and an assay thereof. Patent Application No. 202121027919. Date of Grant 26-06-2024
- S Agrawal, KM Paknikar and D Bodas, “Polymer coated fluorescent semiconductor nanocrystals” 413/MUM/2014. GRANTED
- S Agrawal, KM Paknikar and D Bodas, “Bacteriophage based microfluidic assay for bacterial detection” 414/MUM/2014. GRANTED
- D Bodas, P Kulkarni, B Joshi, “Separation of serum by paper based microfluidics and estimation of different forms of iron using camera phone” 416/MUM/2014. GRANTED
- D Bodas, A process for preparation of polymer coated fluorescent Semiconductor nanocrystals under mathematically derived Process parameters TEMP/E-1/41123/2022-MUM
- Y Karpe, V Gajbhiye, D Bodas and P Dhakephalkar, “Nucleic acid-based test kit to detect viral RNA, DNA, other biomolecules and an assay thereof” TEMP/E-1/31284/2021-MUM
- D Bodas and KM Paknikar, “Method of fabricating microstructures in PDMS” 2782/MUM/2010
- S Agrawal, KM Paknikar and D Bodas, “Polymer coated fluorescent semiconductor nanocrystals” 413/MUM/2014. GRANTED
- S Agrawal, KM Paknikar and D Bodas, “Bacteriophage based microfluidic assay for bacterial detection” 414/MUM/2014. GRANTED
- S Agrawal, KM Paknikar and D Bodas, “Microfluidic biosensor for the detection of pathogens” 415/MUM/2014.
- D Bodas, P Kulkarni, B Joshi, “Separation of serum by paper based microfluidics and estimation of different forms of iron using camera phone” 416/MUM/2014. GRANTED
- V Kulkarni, D Bodas, KM Paknikar, “3D porous scaffolds for cell culture and tissue engineering” 417/MUM/2014.
- D Bodas and KM Paknikar, “Microchip based portable real time polymerase chain reactor” E1/2763/2016MUM.
- Y Karpe, V Gajbhiye, D Bodas and P Dhakephalkar, Nucleic acid-based test kit to detect viral RNA, DNA, other biomolecules and an assay thereof. Patent Application No. 202121027919. Date of Grant 26-06-2024
- S Agrawal, KM Paknikar and D Bodas, “Polymer coated fluorescent semiconductor nanocrystals” 413/MUM/2014. GRANTED
- S Agrawal, KM Paknikar and D Bodas, “Bacteriophage based microfluidic assay for bacterial detection” 414/MUM/2014. GRANTED Bodas, P Kulkarni, B Joshi, “Separation of serum by paper based microfluidics and estimation of different forms of iron using camera phone” 416/MUM/2014. GRANTED
Patent applications:
- S Pandey, and D Bodas, A process for preparation of polymer coated fluorescent Semiconductor nanocrystals under mathematically derived Process parameters TEMP/E-1/41123/2022-MUM
- Development of polymer-lipid hybrid membrane and its application thereof E-11/1073/2024/MUM)
- Development of on-chip model for application in lung-on-a-chip TEMP/E-1/104082/2024-MUM)
Ph. D. Awarded
Sulaxna Pandey: Synthesis of multicolour quantum efficient fluorescent nanocrystals using microreactor for the application in bioimaging. Guide: Dr. D.S. Bodas
Name: Dr. Vandana Ghormade
Designation: Scientist – E
Brief Background :
Dr Vandana Ghormade, Scientist E, Nanobioscience Group focuses her research in the potential applications of nanoscience for delivery, diagnostics and therapeutics. She is working in Nanbioscince since 2007 after completing her Postdoctoral Fellowship from AgroscopeReckenholz–Tänikon Research Station ART, Zürich, Switzerland. She was awarded the CSIR-research associateship in National Chemical Laboratory Pune. She did her doctoral work from National Chemical Laboratory, Pune in Biotechnology. She was a gold medalist in her masters in Botay from University of Pune. Biotechnology. She was a gold medalist in her masters in Botany from University of Pune.
Educational Qualification
- 1996-2000 PhD, Biotechnology, National Chemical Laboratory, University of Pune, India
- 1989 M.Sc, Botany, University of Pune, India; (Gold Medal)
- 1987 B.Sc (Hons), Delhi University, India
Thesis title :Dimorphism in Benjaminiellapoitrasii: a model for the study of morphogenesis and for screening of antifungal agents. (Supervisor- Dr MV Deshpande, National Chemical Laboratory, Pune).
Awards
- Award: Elected as Fellow of Maharashtra Academy of Sciences in 2015
- 2005 Guman Devi Verma Best Woman Scientist (Indian Society of Mycology and Plant Pathology)
- 2001 CSIR-Research Associateship
- 2001 Best Speaker, National conference in fungal diversity and biotechnology, K.V. Pendharkar College, Mumbai.
- 2000 Best Speaker, National Symposium on Basic and Applied Aspects of Plant and Microbial Technology, Modern College, Pune
- 1998 Prize second, Golden Jubilee Research Students Seminar University of Pune
- 1996 CSIR-Research Fellowship
- 1989 Gold Medal, M.Sc Botany, University of Pune
- 1989 Late Milind Gandhi Scholarship, University of Pune
Research Interests
- Nanotechnology involves the creation and utilization of materials, devices or systems on the nanoscale for in healthcare, agriculture and environment. My priority research focuses in the potential applications of nanoscience for delivery, diagnostics and therapeutics.
- Ecological degradation and development of resistance due to pesticide can be mitigated by alternative biocontrol strategies for insect pests. A novel approach using nanoparticles as a delivery system for RNAi is being studied for enhanced uptake and improved stability of siRNA in vitro in cell line studies and in vivo insect bioassays against Helicoverpa, Spodoptera and thrips.
- In case of human health-care opportunistic fungal infections such as aspergillosis and candidiasis are becoming increasingly prevalent among immunocompromised individuals. The early detection and therapy pose a challenge due to the limitations of conventional diagnostic methods and the reported resistance towards antifungals. We have developed Point-of-care, Rapid Lateral Flow assay and ELISA formats for the antigen galactomannan using polyclonal antibodies in combination with gold nanoparticles for invasive aspergillosis diagnosis.
- Detection platforms for mycotoxins and other pathogenic fungi ae being explored using recognition molecules such as peptides, aptamers conjugated to gold nanoparticles.
Bio-imaging with polymer coated quantum dots (robust, photostable, fluorescent nanoparticles) - Application of polymer stabilized magnetic nanoparticles for hyperthermia treatment and drug delivery against cancer.
- Nanoformulation of amphotericin B is patented for the treatment of fungal infections to overcome the problems of toxicity, solubility and resistance.
- Rapid hemostatic bandage is patented for halting blood loss that can contribute to improved survival rate, and reduced disability as well as hospitalization costs.
List of Publications/ Patents/Varieties:
Papers published in refereed journals
- Mayattu K, Rajwade J, Ghormade V. Development of erythromycin loaded PLGA nanoparticles for improved drug efficacy and sustained release against bacterial infections and biofilm formation. MicrobPathog. 2024 Oct 23:107083. doi: 10.1016/j.micpath.2024.107083. Epub ahead of print. PMID: 39454804.
- Gokul Patil, Rutuja Pawar, Vandana Ghormade. Investigation of platelet activation and calcium store release by a topical hemostatic xerogel dressing for improved blood clotting J Appl Polym Sci. 2024;e55194.
- Kamal Mayattu, Vandana Ghormade 2024, Controlled delivery of nikkomycin by PEG coated PLGA nanoparticles inhibits chitin synthase to prevent growth of A. flavus and A. fumigatus. ZNC J Biosci (IF 1.8)
- Kamal and Vandana Ghormade 2023, Evaluation of Silver Nanoparticles for Antifungal Activity Against the Human Fungal Pathogen – Candida albicansKavaka 59 (4): 24-31
- Shraddha Rahi, Vikram Lanjekar, Vandana Ghormade (2023) Rationally designed peptide conjugated to gold nanoparticles for detection of aflatoxin B1 in point-of-care dot-blot assay. Food Chem 413 (2023) 135651
- Henry Kolge, Gokul Patil, Sachin Jadhav Vandana Ghormade (2023) A pH-tuned chitosan-PLGA nanocarrier for fluconazole delivery reduces toxicity and improves efficacy against resistant Int J Biol Macromol 227 (2023) 453–461 B
- Henry Kolge, Kartiki Kadam, Vandana Ghormade (2023) Chitosan nanocarriers mediated dsRNA delivery in gene silencing for Helicoverpaarmigera PesticBiochemPhysiol 189 (2023) 105292
- Gokul Patil, Rutuja Pawar, Sachin Jadhav and VandanaGhormade 2022, A chitosan based multimodal “soft” hydrogel for rapid hemostasis of non-compressible hemorrhages and its mode of action. Carbohydr Polym Technol Appl 4: 100237
- Bhoomika M. Karamchandani, Priya A. Maurya, Sunil G. Dalvi, Samadhan Waghmode, Deepansh Sharma, Pattanathu K. S. M. Rahman, Vandana Ghormade and Surekha K. Satpute (2022) Synergistic Activity of Rhamnolipid Biosurfactant and Nanoparticles Synthesized Using Fungal Origin Chitosan Against Phytopathogens. Front. Bioeng. Biotechnol. 10:917105. doi: 10.3389/fbioe.2022.917105
Book chapters published
- Vandana Ghormade, Vaidehi Bhagwat, Deepali Choudhary, Maheshwari G., and Shivangi Singh. Nanotechnology Interventions for Improved Pesticide and Fertilizer delivery. In:’Nano-Agri-Input Products in Agriculture and Environmental Protection” (eds. .C. Tarafdar, Deepak Kumar, Sanjay K. Singh, K.P. Singh) published by “Apple Academic Press, partnered with CRC Press, a member of the Taylor & Francis Group”. (2023)
- V Ghormade (2022) Nanosensors for detection of Human Fungal Pathogens. In: Nanotechnologies for Infectious Diseases, Editors, S Hameed and S Rehman. Springer Nature, Singapore pp 499-519
Foreign/Indian patents granted
- Nanocarrier for delivery of an ensconced payload, method of its preparation, and applications thereof. Patent No 458152; Date of Grant: October 11, 2023 Vandana Ghormade, Virendra Gajbhiye, K. M. Paknikar
- Chitosan-Based Dressing For Rapid Hemostasis (Patent No 435691) Vandana Ghormade
Foreign/Indian patents filed
- Rationally designed peptides for specific recognition and multiplexed detection of mycotoxin contamination(No. 202221021409)VandanaGhormade
Ph. D. Awarded
Shraddha Rahi: Rapid detection of mycotoxins for ensuring food safety; Guide: Dr. Vandana Ghormade
Google Scholar / Social Media
Name: Dr. Virendra Gajbhiye
Designation: Scientist – F
Brief Background :
Dr. Virendra Gajbhiye has been working in the field of nanomedicine forthe last 15 years. He did his bachelor’s and master’s degrees in Pharmacy. He has a doctoral degree (Ph.D.) in Pharmaceutical Science. He gained postdoctoral research experience at Wisconsin Institute for Discovery, Dept. of Biomedical Engineering, University of Wisconsin, Madison (WI, USA) and Dept. of Biomedical Engineering, Oregon Health and Science University, Portland (OR, USA).
Since December 2013, he is working as a Scientist in Nanomedicine at Agharkar Research Institute, Pune, India. He has worked extensively with polymeric nanoparticles specially dendrimers and mesoporous silica nanoparticles. Currently, his research interests lie primarily in the development of nanotechnology-based gene therapy for the treatment of various cancers and cardiac repair as well as regeneration using Nucleic acid therapy.
Contact Details :
+91-20-25325140(Telephone)
Educational Qualification
- Bachelor of Pharmacy (2004) fromRajiv Gandhi Technical University, Bhopal (MP) Pharmacy
- Master of Pharmacy(2007; Honors) from Dr. H. S. Gour Central University, Sagar (MP)
- Ph. D. in Pharmaceutical Sciences (2011) from Dr. H. S. Gour Central University, Sagar(MP)
- Postdoctoral Research Associate(2012) Wisconsin Institute for Discovery, Dept. of Biomedical Engineering, University of Wisconsin, Madison (WI, USA)
- Postdoctoral Research Associate(2013) Dept. of Biomedical Engineering, Oregon Health and Science University, Portland (OR, USA)
Research Interests
Nanomedicine, Targeted drug/siRNA/miRNA/SSO delivery, Nano-immunosensors, Tissue engineering, Regenerative nanomedicine, Biomedical application of dendrimers & mesoporous silica nanoparticles, Biomaterials, Unimolecular micelles and imaging, Multifunctional polymeric nanoparticles, Nanotheranostics, Nucleic acid therapy, Gene therapy
List of Publications/ Patents/Varieties:
Papers published in refereed journals
- Deshmukh , N. S. Pathan , N. Haldar , S. Nalawade , M. Narwade , K. R. Gajbhiye, V. Gajbhiye. (2025) Exploring intranasal drug delivery via nanocarriers: A promising glioblastoma therapy. Colloids and Surfaces B: Biointerfaces, 245: 114285
- Shaikh, A., P. Kesharwani, and V. Gajbhiye, “Dendrimer as a momentous tool in tissue engineering and regenerative medicine,” J. Control. Release, vol. 346, no. January, pp. 328–354, 2022, doi: 10.1016/j.jconrel.2022.04.008. IF – 11.467
- Narwade, A. Shaikh, K. R. Gajbhiye, P. Kesharwani, and V. Gajbhiye, “Advanced cancer targeting using aptamer functionalized nanocarriers for site-specific cargo delivery,” Biomater. Res., vol. 27, no. 1, p. 42, May 2023, doi: 10.1186/s40824-023-00365-y. IF – 11.3
- Salve, R., Haldar, N., Shaikh, A., Samanta, R., Sengar, D., Patra, S., et al. (2024). MUC1 aptamer-tethered H40-TEPA-PEG nanoconjugates for targeted siRNA-delivery and gene silencing in breast cancer cells. Front. Bioeng. Biotechnol. 12, 1–8. doi: 10.3389/fbioe.2024.1383495. IF – 4.3
- Salve, R., Kumar, P., Chaudhari, B. P., and Gajbhiye, V. (2023). Aptamer tethered bio-responsive mesoporous silica nanoparticles for efficient targeted delivery of paclitaxel to treat ovarian cancer cells. J. Pharm. Sci. 000, 1–10. doi: 10.1016/j.xphs.2023.01.011. IF – 3.7
- Gajbhiye, K. R., Salve, R., Narwade, M., Sheikh, A., Kesharwani, P., and Gajbhiye, V. (2023). Lipid polymer hybrid nanoparticles: a custom-tailored next-generation approach for cancer therapeutics. Mol. Cancer 22, 1–44. doi: 10.1186/s12943-023-01849-0. IF – 27.7
- Deshmukh, V., Pathan, N.S., Haldar, N., Nalawade, S., Narwade, M., Gajbhiye, K.R. and Gajbhiye, V., 2024. Exploring intranasal drug delivery via nanocarriers: A promising glioblastoma therapy. Colloids and Surfaces B: Biointerfaces, p.114285. IF – 5.4
- Korake, S., Salve, R., Gajbhiye, V. and Pawar, A., 2024. αvβ3 integrin-targeted pH-responsive dendritic nanocarriers for enhanced anti-tumor efficacy of docetaxel against breast cancer. Journal of Drug Delivery Science and Technology, 99, p.105946. IF – 4.5
- Varghese, S., Jisha, M.S., Rajeshkumar, K.C., Gajbhiye, V., Alrefaei, A.F. and Jeewon, R., 2024. Endophytic fungi: A future prospect for breast cancer therapeutics and drug development. Heliyon. IF – 3.4
- Salve, R., Haldar, N., Shaikh, A., Samanta, R., Sengar, D., Patra, S. and Gajbhiye, V., 2024. MUC1 aptamer-tethered H40-TEPA-PEG nanoconjugates for targeted siRNA-delivery and gene silencing in breast cancer cells. Frontiers in Bioengineering and Biotechnology, 12, p.1383495. IF – 4.3
- Varghese, S., Jisha, M.S., Rajeshkumar, K.C., Gajbhiye, V., Haldar, N. and Shaikh, A., 2024. Molecular authentication, metabolite profiling and in silico–in vitro cytotoxicity screening of endophytic Penicillium ramusculum from Withaniasomnifera for breast cancer therapeutics. 3 Biotech, 14(3), p.64. IF – 2.6
- Kumar, P., Salve, R., Paknikar, K.M. and Gajbhiye, V., 2023. Nucleolin aptamer conjugated MSNPs-PLR-PEG multifunctional nanoconstructs for targeted co-delivery of anticancer drug and siRNA to counter drug resistance in TNBC. International Journal of Biological Macromolecules, 229, pp.600-614. IF – 7.7
- Kesharwani, P., Sheikh, A., Abourehab, M.A., Salve, R. and Gajbhiye, V., 2023. A combinatorial delivery of survivin targeted siRNA using cancer selective nanoparticles for triple negative breast cancer therapy. Journal of Drug Delivery Science and Technology, 80, p.104164. IF – 4.5
- Fotooh Abadi, L., Kumar, P., Paknikar, K., Gajbhiye, V. and Kulkarni, S., 2023. Tenofovir-tethered gold nanoparticles as a novel multifunctional long-acting anti-HIV therapy to overcome deficient drug delivery-: an in vivo proof of concept. Journal of Nanobiotechnology, 21(1), p.19. IF – 10.6
- Moudgil, A., Salve, R., Gajbhiye, V. and Chaudhari, B.P., 2023. Challenges and emerging strategies for next generation liposomal based drug delivery: an account of the breast cancer conundrum. Chemistry and Physics of Lipids, 250, p.105258. IF – 3.4
- Kesharwani, P., Fatima, M., Singh, V., Sheikh, A., Almalki, W.H., Gajbhiye, V. and Sahebkar, A., 2022. Itraconazole and difluorinated-curcumin containing chitosan nanoparticle loaded hydrogel for amelioration of onychomycosis. Biomimetics, 7(4), p.206. IF – 3.4
- Tiwari, A., Gajbhiye, V., Jain, A., Verma, A., Shaikh, A., Salve, R. and Jain, S.K., 2022. Hyaluronic acid functionalized liposomes embedded in biodegradable beads for duo drugs delivery to oxaliplatin-resistant colon cancer. Journal of Drug Delivery Science and Technology, 77, p.103891. IF – 4.5
- Shaikh, A., Kesharwani, P. and Gajbhiye, V., 2022. Dendrimer as a momentous tool in tissue engineering and regenerative medicine. Journal of Controlled Release, 346, pp.328-354. IF – 10.5
- More, N.A., Jadhao, N.L., Meshram, R.J., Tambe, P., Salve, R.A., Sabane, J.K., Sawant, S.N., Gajbhiye, V. and Gajbhiye, J.M., 2022. Novel 3-fluoro-4-morpholinoaniline derivatives: Synthesis and assessment of anti-cancer activity in breast cancer cells. Journal of Molecular Structure, 1253, p.132127. IF – 4.0
Book chapters published
- Kadu, M., Salve, R., Gajbhiye, K.R., Choudhary, R.K. and Gajbhiye, V., 2023. Nanoparticle-Mediated Plant Bioactives for Cardiovascular Disease. In Advances in Phytonanotechnology for Treatment of Various Diseases (pp. 199-213). CRC Press.
- Kadu, M., Salve, R., Gajbhiye, K.R., Choudhary, R.K. and Gajbhiye, V., 2023. Historical Perspectives and Advances in Phytonanotechnology. Advances in Phytonanotechnology for Treatment of Various Diseases, pp.1-20.
- Haldar, N., Salve, R., Gajbhiye, K.R. and Gajbhiye, V., 2023. Delivery of Antimalarial Phytochemicals by Nanoscale Approaches. In Advances in Phytonanotechnology for Treatment of Various Diseases (pp. 287-305). CRC Press.
- Gajbhiye, K.R., Dhapte, V., Varma, S., Chaudhari, B.P. and Gajbhiye, V., 2022. Redox-responsive nanomedicine for breast cancer therapy. In Targeted Nanomedicine for Breast Cancer Therapy (pp. 407-439). Academic Press.
- Moudgil, A., Jaiswal, N., Gajbhiye, K.R., Gajbhiye, V., Pawar, A.T. and Chaudhari, B.P., 2022. Hypoxia mediated targeted nanomedicine for breast cancer. In Targeted Nanomedicine for Breast Cancer Therapy (pp. 369-406). Academic Press.
- Sayed-Pathan, N.I., Jadon, R.S., Gajbhiye, K.R. and Gajbhiye, V., 2022. Tailored gold nanoparticles for improved control over drug release. In Stimuli-Responsive Nanocarriers (pp. 283-318). Academic Press.
- Poudel, I., Annaji, M., Arnold, R.D., Gajbhiye, V., Tiwari, A.K. and Babu, R.J., 2022. Vesicular nanocarrier based stimuli-responsive drug delivery systems. In Stimuli-Responsive Nanocarriers (pp. 61-86). Academic Press.
- Kumar, P., Salve, R., Gajbhiye, K.R. and Gajbhiye, V., 2022. An overview of stimuli-responsive nanocarriers: State of the art. Stimuli-Responsive Nanocarriers, pp.1-27.
- Salve, R., Kumar, P., Gajbhiye, K.R., Shende, R.A., Chaudhari, B.P. and Gajbhiye, V., 2022. Mesoporous silica nanoparticles-based stimuli-triggered drug release systems. In Stimuli-Responsive Nanocarriers (pp. 237-264). Academic Press.
- Jadon, R.S., Jadon, P.S., Bhadauria, V., Sharma, V., Bharadwaj, S., Sharma, M., Gajbhiye, K.R. and Gajbhiye, V., 2022. Solid–lipid nanoparticles based vehicles for stimuli inspired delivery of bioactives. In Stimuli-responsive nanocarriers (pp. 265-282). Academic Press.
- Salve, R., Gajbhiye, K.R., Babu, R.J. and Gajbhiye, V., 2022. Carbon nanomaterial-based stimuli-responsive drug delivery strategies. In Stimuli-Responsive Nanocarriers (pp. 367-392). Academic Press.
- Moudgil, A., Shende, R.A., Pawar, A.T., Gajbhiye, K.R., Gajbhiye, V. and Chaudhari, B.P., 2022. Quantum dots based vehicles for controlled drug release in conjunction with bio-imaging. In Stimuli-Responsive Nanocarriers (pp. 197-236). Academic Press.
- Narwade, M., Gajbhiye, V. and Gajbhiye, K.R., 2022. Protein nanocapsules as a smart drug delivery platform. In Stimuli-Responsive Nanocarriers (pp. 393-412). Academic Press.
Books Edited
- Advances in Phytonanotechnology for Treatment of Various Diseases. Prashant Kesharwani, Virendra Gajbhiye. Publication date:- 2023/9/29. Publisher:- CRC Press. ISBN 9781032137469.
- Stimuli-Responsive Nanocarriers: Recent Advances in Tailor-Made Therapeutics. Virendra Gajbhiye, Kavita Gajbhiye, Seungpyo Hong (Eds.) Academic Press. 1st Edition – January 4, 2022. Elsevier. USA. Paperback ISBN: 9780128244562
- Bodas D, Gajbhiye V. 2024. Microfluidics-aided technologies: Platforms for the next generation biological applications. Academic Press. Elsevier
Indian patents granted
- Nanocarrier for delivery of an ensconced payload, method of its preparation, and applications thereof. Patent No 458152; Date of Grant: October 11, 2023 Vandana Ghormade, Virendra Gajbhiye, K. M. Paknikar
- Y Karpe, V Gajbhiye, D Bodas and P Dhakephalkar, Nucleic acid-based test kit to detect viral RNA, DNA, other biomolecules and an assay thereof. Patent Application No. 202121027919. Date of Grant 26-06-2024
Patent Applications
Endophytic Penicillium setosum SVWS1 derived anticancer compound for breast cancer therapeutics. Patent Application No. 202421003897
Ph. D. Awarded
Rajesh Salve: Targeted co-delivery of siRNAs for effective therapeutic outcome against metastatic ovarian cancer. Guide: Dr. V. Gajbhiye
Other important information
- Dr. V. Gajbhiye elected as Fellow of Maharashtra Academy of Sciences (MASc). Fellowship No. ELF1196.
- Vocational Excellence Award from Rotary Club, Pune for contributions to research in Nanotechnology and its applications in healthcare.
- Control Release Society (CRS, Indian Chapter) 2nd Best Poster Award 2023 with cash price of INR 25,000.
- Dr. Virendra Gajbhiye appears in the list of Top 2% Scientists list released by Stanford University. His inclusion is for the fourth consecutive year.
- V. Gajbhiye: Keynote talk entitled “Multilayered nanoconstructs for targeted delivery of drugs/siRNA to treat various cancers” 3rd International Conference on Materials Science and Engineering”. September 26-27, 2024 in Amsterdam, Netherlands
Google Scholar / Social Media
Name: Dr. Monali Rahalkar
Designation: Scientist – E
Brief Background :
I completed my PhD from University of Konstanz, Germany, where I studied methane oxidizing bacteria from Lake Constance. During my postdoctoral work, at University of Bremen, I worked on nitrogen fixing bacteria associated with rice roots.
I started my work in this institute in September 2013, and my main focus isto study, isolate and cultivate novel and environmentally important micro-organisms. My team is currently focused on ‘methanotrophs’ or methane oxidizing bacteria, present in various environments. Methanotrophs oxidize methane and perform the important function of methane oxidation in the environment. They use C1 compounds as their sole source of C and energy. These act as natural bio-filters of methane and are instrumental in methane mitigation.
I started working on methanotrophs from Indian (tropical) rice fields which are one of the key hotspots of methanotrophs. We have been successful in cultivation of various methanotrophs which also involves several new taxa. The methanotrophs would be explored for a variety of bioenergy and biotechnological applications. We are also exploring the genomics of various novel species. We also use various approaches like metagenomics to study the in-situ communities.
Contact Details :
0091-020-25325119 (Telephone)
Research Gate: https://www.researchgate.net/profile/Monali_Rahalkar2Twitter@MonaRahalkar
Educational Qualification
- B.Sc Microbiology (Ist class, 2nd rank in Pune University, Microbiology) 1997
- M.Sc Microbiology (Ist class with distinction, 6th rank in Pune UniversityMicrobiology) 1999
- PhD Microbial Ecology 2007 University of Konstanz, Konstanz, Germany (Research guide: Prof. Bernhard Schink).
Research Interests
Methanotrophs (methane oxidizing bacteria): Diversity, cultivation and genomics
- Climate change is currently one of the most of important threats to the living world. Methane is the second most important greenhouse gas and has a higher global warming capacity than CO2. Methane is naturally oxidized by methanotrophs which use methane as the sole source of carbon and energy.
- My current research work is focused on methanotrophs. We are studying various aspects such as their diversity in various habitats, cultivation of methanotrophs, description of cultures and investigating their applications in various fields of bioenergy and biotechnology.
- We are the first laboratory in India to host more than 50 pure strains of methanotrophic bacteria. The isolates belong to nine different genera, of which two novel genera have been described from India by us (Methylocucumis and Methylolobus). We believe that this is the first culture collection of methanotrophic bacteria in India. All of the methanotrophic isolates are being explored for diverse bioenergy, biotechnological and environmental applications including methane mitigation from various sources, gas to liquid biofuel production, single cell protein production, etc.
Methanotrophs in Methane Mitigation
- We are planning to use methanotrophs as novel bio-inoculants for methane mitigation in rice fields and landfills. Further, we would also use bio-stimulation for stimulating the native methanotroph populations which would help in green house has reduction from this source.
- Our further focus would be study of methanotrophs from landfills and stimulating methanotrophs from the existing landfills and design of methanotrophicbiocovers.
Methanotrophs for Biotechnological applications
We are trying to addvalue to the methane from waste natural gas or biogas, i.e. methane valorization, to products such as biodiesel and single cell proteins, are being explored. In India, as methanotrophs were not been cultivated in routine practices, probably, such applications have not been explored.
List of Publications/ Patents/Varieties:
Papers published in refereed journals
- Rahalkar, M. C., Khatri, K., Pandit, P., Bahulikar, R. A., & Mohite, J. A. (2021). Cultivation of Important Methanotrophs From Indian Rice Fields. Frontiers in Microbiology, 12, 669244. https://doi.org/10.3389/fmicb.2021.669244
- Khatri, K., Mohite, J., Pandit, P., Bahulikar, R. A., & Rahalkar, M. C. (2021). Isolation, Description, and Genome Analysis of a Putative Novel Methylobacter Species (‘Ca. Methylobacter coli’) Isolated from the Faeces of a Blackbuck (Indian Antelope). Microbiology Research, 12(2), 513-523. https://doi.org/10.3390/microbiolres12020035
- Mohite JA, Manvi SS, Pardhi K, Khatri K, Bahulikar RA & Rahalkar MC (2023) Thermotolerant methanotrophs belonging to the Methylocaldum genus dominate the methanotroph communities in biogas slurry and cattle dung: A culture-based study from India. Environmental Research 228: 1-6. https://doi.org/10.1016/j.envres.2023.115870
- Mohite JA, Manvi SS, Pardhi K, Bahulikar R, Patange S, Deshpande S, Joshi M, Kulkarni S & Rahalkar MC (2023) Diverse Type I and Type II methanotrophs cultivated from an Indian freshwater wetland habitat. International Microbiologyhttps://doi.org/10.1007/s10123-023-00415-4
- Mohite JA, Khatri K, Pardhi K, Manvi SS, Jadhav R, Rathod S & Rahalkar MC (2023) Exploring the Potential of Methanotrophs for Plant Growth Promotion in Rice Agriculture. Methane 2: 361-371.
- Rahalkar, M.C., Mohite, J.A., Pardhi, K. ,Manvi,SS., Kadam, S.S., Patil, Y.Y (2024) Insights into Methylocucumis oryzae, a Large-sized, Phylogenetically Unique Type Ia Methanotroph with Biotechnological Potential. Indian J Microbiolhttps://doi.org/10.1007/s12088-024-01347-x
- Rahalkar, M.C., Khatri, K., Pandit, P. and Mohite, J. Polyphasic Characterization of Ca. Methylomicrobium oryzae: A Methanotroph Isolated from Rice Fields. Indian J Microbiol (2024). published online 29th August 2024 https://doi.org/10.1007/s12088-024-01381-9
Ph. D. awarded:
- Rahalkar, M. C., Khatri, K., Pandit, P., Bahulikar, R. A., & Mohite, J. A. (2021). Cultivation of Important Methanotrophs From Indian Rice Fields. Frontiers in Microbiology, 12, 669244. https://doi.org/10.3389/fmicb.2021.669244
Other important information
- Monali Rahalkar was awarded DURGA Puraskar by Loksatta, October 2022
- Rotary Club of Pune Pride vocational excellence award to M. C. Rahalkar; International Women’s Day- 2024
- Dr. M. C. Rahalkar is nominated as Member of Technical Expert Committee on “Energy Bioscience, Environmental& Forest Biotechnology”, DBT, India (from April 2022-2025)
Technologies Transferred
- Nucleic acid-based test kit to detect viral RNA, DNA, and other biomolecules. This technology has been transferred to FastSense Innovations Pvt. Ltd., Pune.
- Technologies transferred to SKR Agro, Wardha, (1) Oil nanoformulation for mealy bug control, (2) Copper nanoparticles as antimicrobial agent (3) Zn-chitosan nanoparticles formulation (Zn-CNP) as a foliar spray for delivery of essential micronutrient in crop
New Extramural Project Sanctioned
- Candidate Chikungunya virus vaccine to test efficacy of E2 protein-loaded PLGA-PEG nanoparticle as a candidate vaccine in adult and aged mouse model, DST Nanomission: PI: Yogesh A. Karpe, Co-PI: Virendra Gajbhiye, Fund 66.47 lakh. March 2022 to March 2025.
- Determine the mechanism of Autophagy-related gene-1 (Atg1) in the metabolism of lipids, ICMR, PI: Bhupendra Shravage, Co-PI: Yogesh A. Karpe, Fund: 58.57 lakh. March 2024 to March 2026
- Application of methanotrophs in rice agriculture for methane mitigation and plant growth promotion. POWER fellowship SERB. Monali C. Rahalkar (PI) 38.1 lakhs. SPF/2022/000045. Nov 2022-Nov 2025.
- Demystifying the impact of virus infection on the blood coagulation system and exploring the possibility of drug repurposing to treat viral diseases”. Department of Biotechnology, PI: Yogesh Karpe, Co-PI: Bhupendra Shravage. Fund: Rs. 5417840, Duration: 25-09-24 to24-09-27
- Therapeutic investigations and isolation of bioactives from Haplanthodes species, the wild relatives of Kalmegh. Rajiv Gandhi Science and Technology Commission, MH PI: R. K. Chaudhary, Co-PI: Virendra Gajbhiye. Rs. 2600000 February2023to February2026
- Multifaceted therapy for cardiac regeneration post infarction through delivery of nucleic acids and bioactives via targeted nanocarriers Science and Engineering Research Board, Govt. of India. PI: Virendra Gajbhiye Fund: Rs. 7700000 November 2023 to November 2026
- Potential stemness genes knockout through CRISPR-Cas9 technology in triple-negative breast cancer cells via multitalented nano-hybrids. Indian Council of Medical Research (ICMR), Govt. of India PI: Virendra Gajbhiye. Approved
Google Scholar / Social Media
Name: Dr. Yogesh Karpe
Designation: Scientist – E
Brief Background :
- Scientist, Agharkar Research Institute, Pune 2014-01-01 to till date
- DST INSPIRE Faculty: National Institute of Virology, 2012-06-14 to 2013-12-31
- Postdoctoral Associate, Center for Infectious Diseases and Molecular Medicine, Collage of Veterinary Medicine, Virginia Tech, Blacksburg, VA, USA, 2011-05-25 to 2012-06-12
Contact Details :
020-25325086 (Telephone)
Educational Qualification
- Ph.D. National Institute of Virology, Year 2012, Field of Study: Virology
- M.Sc. Department of Zoology, University of Pune, Year 2006, Field of Study: Zoology
Research Interests
- Replication and pathogenesis of positive sense RNA viruses.
- Novel approaches for development of viral vaccines.
Key Publications:
Papers published in refereed journals
- Patil R, Salunke P, Karpe YA. (2023) Unravelling the Tripartite Interactions Among Hepatitis E Virus RNA, miR-140 and hnRNP K. Journal of Molecular 15;435(10):168050
- Karpe, Y. A. (2024). Processing of the hepatitis e virus ORF1 nonstructural polyprotein. Frontiers in Virology, 3: 1327745
- Nangare, R. A., Gajbhiye, V., & Karpe, Y. A. (2024). Role of miRNAs in the Chikungunya virus replication and pathogenesis. Frontiers in Virology, 4: 1386580.
- Patra S. Gajbhiye, V., & Karpe, Y. A. (2024). Assessment of heat-killed E. coli expressing Chikungunya virus E2 protein as a candidate vaccine for dual protection against Chikungunya virus and E. coli. Frontiers in Immunology, accepted
Foreign/Indian patents granted/filed
Y Karpe, V Gajbhiye, D Bodas and P Dhakephalkar, Nucleic acid-based test kit to detect viral RNA, DNA, other biomolecules and an assay thereof. Patent Application No. 202121027919. Date of Grant 26-06-2024
Ph. D. awarded
- Rajashree Patil: Roles of microRNAs in Hepatitis e virus replication. Guide: Dr. Y. A. Karpe
Other important information
Dr. Yogesh Karpe is nominated to serve in the DST-INSPIRE faculty Fellowship Selection Committee for 2 years.
Google Scholar / Social Media
Name: Dr. Sachin Jadhav
Designation: Scientist – E
Brief Background :
Scientific Career
- Scientist –D, Agharkar Research Institute Pune-Present
- Research Scientist,Stem Cell Research and Therapy. Dept. of Hematology, SGPGIMS, Lucknow, Sept 2008 to Nov.2013.
- Post-doctoral Fellow, Wayne State University, MI,USA, 2007.
- Post-doctoral Fellow . Temple University, PA, USA (worked in collaboration with University of Pennsylvania, PA,USA), July 2005 to Dec.2006
Awards
- New Investigator’ award received in 98 th AACR (American Association for Cancer Research ) Annual Meeting 2007 held at LA, CA,USA
- Indian Veterinary Research Institute (IVRI)-JRF
- Agricultural scientist recruitment board certification for lectureship
- Bhrid Bhartiya Samaj(Gold Medal)Scholarship for post-graduate studies
- Mahatma Phule merit cum scholarship for graduate studies
Contact Details :
+ 91-20-25325139 (Telephone) , 0091 20 25651542 (Fax)
Educational Qualification
- PhD in Veterinary Pharmacology (2005) from Indian Veterinary Research Institute (IVRI),Bareilly ,UP Institute (India)
- MVSc in Veterinary Pharmacology (2001) from Marathwada Agriculture University ,MS (India)
Research Interests
Laboratory animal care and development of animal models
- The main activity of animal facility staff is to breed and maintain the laboratory animal colonies in complete compliance with the CPCSEA and in-house animal care principles, rules, regulations and guidelines.
- We have developed various animal disease models such as acute renal failure, chronic renal failure, myocardial infarction,experimental autoimmune encephalomyelitis, diabetes, osteochondral defect, breast cancer, alzheimer’s disease, inflammation induced anaemia,, lethal hemorrhagic injury, chronic wound excision etc for testing of various biological active molecules.
Stem cell research and therapy
- We have isolated stem cells from various tissue sources viz.fetal kidney, fetal heart and bone marrow. We further tested their therapeutic efficacy in different animal disease models viz. acute renal failure, myocardial infarction, experimental autoimmune encephalomyelitis and global heart failure.
- We are now focusing on the development of novel methods for non viral transfection of cardiac specific transcription factors to induce cardiomyocytes from cardiac fibroblast in ischemic myocardial infraction settings.
miRNA based therapeutics for various diseases
- We are working to develop miRNA based therapeutics for acute and chronic renal failure, and had intramural project on the same
- We evaluated potential of nanoparticles based delivery of miRNAs for myocardial repair and
- Recently we are interested to unveil the miRNA mediated signalling molecules that regulate the cross talk between autophagy and apoptosis after myocardial infarction
Biomedical Applications of nanotechnology
- WE evaluated potential of bacterial cellulose based bilayered scaffolds in a rat model of osteochondral defects and showed progressive regeneration of cartilage
- We determined anticancer activity of truncated domain of SMAR1 protein (His 5) loaded on Carbon nanospheres (CNS) in mice bearing breast tumours
- We are now studying combination therapy of surface functionalized Lanthanum Strontium Manganese Oxide nanoparticles mediated hyperthermia along with doxorubicin for the treatment of breast cancer
List of Publications/ Patents/Varieties:
Papers published in refereed journals
- D.Khairnar,A.Padhye,V.Madiwal,A.Jha,S.H.Jadhav,J.M.Rajwade.(2023)Cyclicβ-hairpinpeptideloadedPLGA nanoparticles:apotentialanti-amyloidtherapeutic.Materials Today Communications35:106322.doi.org/10.1016/j.mtcomm.2023.106322(IF:3.8)
- Padhye-PendseA,UmraniR,PaknikarK,JadhavS,RajwadeJ.LifeSci.2024Jun15;347:122667.(IF:4.6)
- S. Tawre, A. Padhye, S. Chakraborty, N. Kulkarni, G. Bose, S. Mittal, U. Jadhav, S. Jadhav, J.M. Rajwade, K. Pardesi, Bioactive Curcuma aromatica-stabilized silver nanoparticles embedded chitosan dressing with improved antibacterial, anti-inflammatory, and wound healing properties. Carbohydrate Polymer Technologies and Applications 8 (2024) 100570.
- Savardekar A, Fernandes E, Padhye-Pendse A, Gupta T, Pol J, Phadke M, Desai S, Jadhav S, Rajwade J, Banerjee A. Adipocytes Promote Endometrial Cancer Progression Through Activation of the SIRT1-HMMR Signaling Axis. Molecular Carcinogenesis. 2024 1002/mc.23815. Epub ahead of print. PMID: 39254492.
- Henry Kolge, Gokul Patil, Sachin Jadhav Vandana Ghormade (2023) A pH-tuned chitosan-PLGA nanocarrier for fluconazole delivery reduces toxicity and improves efficacy against resistant Int J Biol Macromol 227 (2023) 453–461 B
- Gokul Patil, Rutuja Pawar, Sachin Jadhav and VandanaGhormade 2022, A chitosan based multimodal “soft” hydrogel for rapid hemostasis of non-compressible hemorrhages and its mode of action. Carbohydr Polym Technol Appl 4: 100237
- Shete, N.Ghatpande , M.Varma , P.Joshi , K. Suryavanshi, A. Misar, S. Jadhav , P.Apte , P. Kulkarni . Chronic dietary iron overload affects hepatic iron metabolism and cognitive behavior in Wistar rats J Trace Elem Med Biol doi: 10.1016/j.jtemb.2024.127422. Epub 2024 Mar 2.
- Singh, K. Patel , A.Navalkar , P. Kadu, D. Datta , D. Chatterjee , S. Mukherjee , A. Shaw , S. Jadhav , S. K Maji.(2023) Amyloid fibril-based thixotropic hydrogels for modeling of tumor spheroids in vitro. Biomaterials 295(10):122032.
- Neha Kulkarni-Dwivedi, R Patel , B.Shravage , R.D. Umrani, K.Paknikar , S. H Jadhav. Hyperthermia and doxorubicin release by Fol-LSMO nanoparticles induce apoptosis and autophagy in breast cancer cells Nanomedicine (Lond)2022 Oct;17(25):1929-1949.doi: 10.2217/nnm-2022-0171.
- R J Waghole,AV Misar, F Khan , D G Naik , S H Jadhav . In vitro and in vivo anti-inflammatory activity of Tetrastigmasulcatum leaf extract, pure compound and its derivatives. Inflammopharmacology 2022 Feb;30(1):291-311.
- A Navalkar ,S Pandey,NSingh,KPatel,DDatta,B Mohanty ,S Jadhav,PChaudhari,S.K Mazi. Direct evidence of cellular transformation by prion-like p53 amyloid infection. J Cell Sci. 2021 Jun 1;134(11)
Ph. D. awarded
- Neha Kulkarni: Studies on surface functionalized Lanthanum Strontium Manganese Oxide nanoparticles mediated hyperthermia for the treatment of breast cancer Guide: Dr. S. H. Jadhav
Google Scholar / Social Media
Name: Dr. Pratibha
Designation: DST INSPIRE Faculty (March 2022- Present)
Brief Background :
- Postdoctoral Research, University of Konstanz, Germany (2019-2021)
- Ph.D. in Chemistry, IIT Kanpur (2018)
Contact Details :
Research Gate: https://www.researchgate.net/profile/Pratibha-Jhaba
Educational Qualification
- Postdoctoral Research, University of Konstanz, Germany (2019-2021)
- Ph.D. in Chemistry, IIT Kanpur (2018)
Research Interests
Research in nucleic acid chemistry plays a critical role in understanding fundamental biological processes, developing diagnostic tools, and designing therapeutic interventions. Here are some of my research interests in nucleic acid chemistry:
- Functional nucleoside analogs and nucleic acids
- DNA nanotechnology: DNA functionalized nanoparticles
- Nucleic acid-protein interactions
- Nucleic acid-based diagnostics
Depending on your specific background, skills, and interests, you can explore various aspects of nucleic acid chemistry and contribute to advancing our understanding of these essential molecules in chemical biology.
Please feel free to contact me if you are interested in a PhD or graduate project in our group.
List of Publications/ Patents/Varieties
- A. Butterworth, Pratibha, A. Marx, D. K. Corrigan ‘’Electrochemical Detection of Oxacillin Resistance using Direct-labelling Solid-phase Isothermal Amplification’’ ACS Sens. 2021, 6, 3773–3780.
- K. Yadav, Pratibha, T. G. Gopakumar, S. Verma “Solution-Processed Large-Area Ultrathin Films of Metal-Coordinated Studied metal-nucleobase interactions by Electron-Rich Adenine-Based Ligand” J. Phys. Chem. C 2019, 123, 20922−20927.
- Pratibha, M. Shukla, G. Kaul, S. Chopra, S. Verma. “Nucleobase Soft Metallogel Composites with Antifouling Activities Against ESKAPE Pathogens” ChemistrySelect 2019, 4, 1834-1839.
- B. Mohapatra, Pratibha, K. R. Saravanan, S. Verma “2,6-Diaminopurine-Zinc Complex for Primordial Carbon Dioxide Fixation” Inorg. Chim. Acta 2019, 484, 167-173.
- Pratibha, S. Singh, S. Sivakumar, S. Verma “Purine-Based Fluorescent Sensors for Imaging Zinc Ions in HeLa Cells” Eur. J. Inorg. Chem. 2017, 4202-4209.
- B. Mohapatra,† Pratibha,† S. Verma “Directed Adenine Functionalization for Creating Complex Architectures for Material and Biological Applications” Chem. Commun. 2017, 53, 4748-4758.
- J. Kumar, Pratibha, S. Verma “Crystallographic Signatures of Silver-Purine Frameworks with an Azide Functionality” Inorg. Chim. Acta 2016, 452, 214-221
- Pratibha, S. Verma “Imine Component Based Modified Adenine Nucleobase-Metal Frameworks” Cryst. Growth Des. 2015, 15, 510-516.
Name: Shailesh Waghmare
Designation: Laboratory Assistant – C
Job Description :
Laboratory Documentation
- Maintaining / Up-dating / Record Keeping of all the work related to lab documentation
- Processing all types of official documents
- Submitting / Bringing letters, documents etc.
- Communicating: Requests (wrote note / mailed) &/or follow-ups (by mail / telephonically)
- Computer Data entry & Printing work as per evident in the computer records
- Miscellaneous lab documentation work
- Documentation related or Any other type of work told by Scientists
Laboratory Management
- Bio-hazard waste disposal management
- Management of local purchase and procurement of commonly required lab-ware’s, its surfing, quotation analysis, raising requisition, material follow-up, Issuing & work space management for its storing & stocking
- Managing Group activities & Supervising all about lab cleanliness, lab maintenance, record tracing, searching misplaced things, enquiring lab-ware damage etc.
- Miscellaneous lab management work
- Any other type of lab management related work told by Scientists
Scientific Assistance
- Routine microbiology & sub- culturing work
- Experimental work assigned by Scientist
- Routine Instrumental duty assigned for AAS & XRD Sample analysis
- Other institute’s Nanoparticle Sample Analysis / Characterisation / Testing
- Miscellaneous Scientific Assistance work
- Represented ARI during National Science day
Contact Details :
9423218215(Telephone)
Educational Qualification
- M.Sc. (Microbiology) + Post Graduate Diploma in Computational Biology
Publications/ Achievements/ Awards
Publication: In the journal Geochemistry, Geophysics, Geosystems, the title of the paper is “Implications of microbial thiosulfate utilization in red clay sediments of the Central Indian Basin – The Martian Analogy,” this is my first official publication for assisting the Scientist in his work.
Award: Got our Institute’s Sukhatme Award for Best Employee
Achievement: Assisting Scientist’s In COVID-19 Testing & Data Entry Related Work
Name: Rupali Bambe
Designation: Technical Assistant - B
Job Description :
Molecular techniques in Virology and animal handling expertise in vaccine development.
Contact Details :
+91-9552559349 (Telephone)
Educational Qualification
- B.Sc. Microbiology
- M.Sc. Microbiology
Publications/ Achievements/ Awards
Nil
Name: Atul Dwivedi
Designation: Technical Assistant - B
Job Description :
Electron Microscopy, Energy Dispersive Spectroscopy facility.
Contact Details :
020-25325088 (Telephone)
Educational Qualification
- B.E. in Electronics & Communication (RGPV, Bhopal)
- PGDBM (Mumbai University)
- M.Tech. in Microelectronics (BITS-Pilani)
Publications/ Achievements/ Awards
Name: Aazam Shaikh
Designation: Junior Research Fellow
Brief Background :
- M.Sc. Biotechnology (2014-2016),
- Worked in the field of Bioanalytical Chemistry as Project Assistant at Symbiosis School of Biological Sciences (SSBS, Pune),
- Worked in the field of Cancer Biology as Project Assistant at National Centre for Cell Sciences (NCCS, Pune),
- Worked in the research area of Project Fellow at Indian Institute for Science Education and Research (IISER, Pune)
Contact Details :
Educational Qualification
- B.Sc. Biotechnology from Nowrosjee Wadia College, Pune.
- M.Sc. Biotechnology from Modern College, Ganeshkhind.
- GATE 2017
- GATE 2020
Research Interests
- Regenerative Biology; Cardiac Repair and Regeneration.
- My interests lie, in understanding the fine-tuned mechanisms of cellular growth, differentiation, and proliferation, encompassing various cell types. At present, my study in regenerative biology involves the use of nanoparticles for the delivery of miRNAs for cardiac muscle regeneration after myocardial injury. Cardiomyocytes are muscle cells of the heart which are terminally differentiated, and responsible for the proper functioning of the heart having limited regenerative potential. Myocardial infarction decreases the population of the cardiomyocytes significantly, which leads to scarring or fibrosis of the heart muscle.
List of Publications/ Patents/Varieties
Not Yet
Name: Aishwarya Padhye
Designation: DST-INSPIRE Fellow (JRF)
Brief Background :
- B.Sc. Biotechnology gold medalist
- Qualified GATE-2017 and DBT-BET
- Selected and participated in ABLE-India’s BEST-2016
- One year teaching experience as an assistant professor at MGM’s-Institute of Biosciences and technology, Aurangabad.
Contact Details :
Educational Qualification
- M.Sc. Biotechnology
Research Interests
Application of metal oxide nanoparticles in the treatment and/or prevention of diabetic complications mainly diabetic nephropathy.
List of Publications/ Patents/Varieties
Not Yet
Name: Bhushan Khairnar
Designation: Senior Research Fellow (UGC)
Brief Background :
I have completed my M.Sc. (Biochemistry) year 2009 from Kavayitri Bahinabai Chaudhari North Maharashtra University (NMU), Jalgaon. Then, I joined a pharmaceutical company named S.A. Pharma located in Silvassa. There I was working as microbiologist for 2 years. In the year 2013, I qualified State Eligibility Test (SET) conducted by Pune University. During the same year, I joined NMU, Jalgaon as assistant professor (3 years) in the School of Life Sciences. In 2016, I have joined Agharkar Research Institute Pune in Nanobioscience group for pursuing Ph.D. under the guidance of Dr. Jyutika Rajwade.
Contact Details :
Educational Qualification
- M.Sc. (Biochemistry)
- SET (University of Pune)
- NET JRF (UGC Delhi)
- ASRB-NET (Delhi)
Research Interests
I am working on peptide therapeutics for Alzheimer’s disease (AD). AD is a neurodegenerative disease in which the β-amyloid peptide (Aβ42) aggregates in the brain to form amyloid plaques, which leads to the death of nerve cells. Currently, no therapeutic molecules are available in the market to treat AD patients. The approaches to disrupt Aβ42 fibrillar aggregates are small molecules, nanoparticles, metal chelators, peptides, and chaperones, etc.
Our work comprises the design of peptide-based inhibitors especially cyclic peptides (CPs). We choose CPs because they are proteolytically stable, precise, and tight binding with Aβ42 aggregates and they can cross the Blood-Brain Barrier (BBB). The inhibitor peptide sequences design from the amyloid core-forming segment 16KLVFF21as a template of Aβ42. The synthesis of peptide inhibitors using peptide chemistry, and its characterization against Aβ42 for fibrils disruption. The techniques we are using for peptide synthesis are solid-phase peptide synthesis. We purify peptides using high-performance liquid chromatography. Aβ42 fibrils inhibition is studying by a dye-binding Thioflavin-T assay, Congo red, and ANS assay. Peptide conformational study by Circular Dichroism Spectroscopy, fibrils morphology by Transmission Electron Microscopy, and rescuing of Aβ42 induced cell cytotoxicity of cyclic peptides are studying by MTT assay.
List of Publications/ Patents/Varieties
Nil
Name: Pooja Salunke
Designation: CSIR-JRF
Brief Background :
- M.Sc. Project dissertation at National AIDS Research Institute
- Topic: “B CELL AND TFH CELL PROFILING IN HIV-1 INFECTION”
Contact Details :
Educational Qualification
- B.Sc.: Microbiology (Abasaheb Garware College, Pune)
- M.Sc.: Virology (National Institute of Virology, Pune)
Research Interests
Exploring Non-pathogenic protozoa as a eukaryotic platform for protein expression
List of Publications/ Patents/Varieties
Nonprogressive HIV-1 Infection Is Associated with Expansion of IL-21R Expressing Class-Switched Memory B Cells
https://doi.org/10.1089/aid.2019.0015
Name: Pooja Suryavanshi
Designation: Ph.D. Student (UGC-JRF)
Brief Background :
I got introduced to the field of Nanotechnology during my Master’s dissertation, where I worked on biological synthesis of nanoparticles and its antimicrobial effect on foodborne pathogen. While working as a Research assistant, I have explored the field of phytosecondary metabolites where in the effect of gamma irradiation on Artemisia annua plant was assessed for increased artemisinin content (an antimalarial metabolite).
Having keen interest in animal cell culture studies, recently I have joined as a Ph.D. student in Nanobioscience group. I am working on a 3D porous scaffold for cell growth in 3D and assessment of cancer immunotherapy.
Contact Details :
Educational Qualification
- M.Sc. Biotechnology (2016)Sant Gadge Baba Amravati University, Amravati.
- B.Sc. Biotechnology (2014)Sant Gadge Baba Amravati University, Amravati.
Research Interests
Microfluidics based 3D cell culture is an emerging platform widely explored in the field of tissue engineering, drug testing, drug discovery, regenerative medicine and microfluidic 3D cell culture: Organ on a chip.3D scaffold provides natural tissue like environment wherein 3D architecture, controlledperfusion of nutrients and growth factor along with oxygen diffusion is provided which more closely mimics in vivo scenario.
In 3D cell culture, cells are allowed to communicate with its surrounding which enables the culture of multiple cell type.
My current research work focuses on the fabrication of PDMS based scaffold for development of ovarian cancer T- cell co-culture for assessment of cancer immunotherapy.
List of Publications/ Patents/Varieties
- Suryavanshi P, Pandit R, Gade A, Derita M, Zachino S, Rai M (2017). Colletotrichum sp. mediated synthesis of sulphur and aluminium oxide nanoparticles and it’s in vitro activity against selected food-borne pathogens. LWT Food science and technology.81 188 194.
- Patil A S, Suryavanshi P, Fulzele D(2018). Evaluation of Effect of Gamma Radiation on Total Phenolic Content, Flavonoid and Antioxidant Activity of In Vitro Callus Culture of Artemisia annua. Natural Products Chemistry and Research. 10.4172/2329-6836.1000345.
Name: Snehal Kulkarni
Designation: Junior Research Fellow
Brief Background :
- Academic project during post graduation on “Process optimization, production and evaluation of antimicrobial potential of lantibiotic obtained by Lactobacillus sp.
- Lecturership (C.H.B.) at Shivchhatrapati College, Aurangabad.(2017-2018)
- Isolation of pigment producing Actinomycetes from soil and their applications. (2018).
- Lecturership (C.H.B.) at Badrinarayan Barwale College, Jalna.
- Screening of Marine Actinomycetes and their applications. (2019)
- Screening of marine Actinomycetes producing industrial enzymes and applications of enzymes. (2019)
Contact Details :
Educational Qualification
- B.Sc. Microbiology, Chemistry, Botany (2015), Dr. Babasaheb Ambedkar Marathwada University, Aurangabad.
- M.Sc. Microbiology (2017) , Dr. Babasaheb Ambedkar Marathwada University, Aurangabad.
- Graduate Aptitude Test in Engineering (GATE) Life Science. 2019
- Biotechnology Eligibility Test- DBT-JRF 2019
Research Interests
Production, nanodelivery and validation of viral vaccine against nodavirus of fish.
List of Publications/ Patents/Varieties
- International Journal of Current Research in Life Science, “Isolation of Pigment Producing Actinomycetes from Soil and Screening Their Antibacterial Activities against Different Microbial Isolates”, 2018.
- Journal for Advanced Research in Applied Sciences, volume-5, “Lip Balm Production from Pigment Producing Actinomycetes”, April-2018.
Name: Tanmayee Sathe
Designation: Research Student (UGC-JRF)
Brief Background :
I have always been keen on finding answers to questions, taking up challenges and learning new things in life. Research is what I have always had keen interest in and hope to contribute to the society from my work.
After my post-graduation, I continued my preparation for competitive exams with a goal to persue higher education. Meanwhile I worked as Project-JRF in Abasaheb Garware College. I cleared the CSIR-NET exam in Dec-2019 and was awarded UGC fellowship.
I have recently started my journey as a research student at the Nanobioscience group and hope to gain more knowledge during this journey.
Contact Details :
Educational Qualification
- M.Sc. Biotechnology (2017) from Abasaheb Garware College, Pune
- B. Sc. Biotechnology (2013) from Abasaheb Garware College, Pune
Research Interests
Microfluidics is an evolving field with its applications extending to many other fields of study. The changes in the properties and behavior of fluids at micro or nano level are interesting and can be applied to other techniques in order to explore the properties.
My current research study involves microfabrication of porous and non- porous capillaries in order to explore the capillary behavior of liquids through them.
List of Publications/ Patents/Varieties
Name: Vaibhav Madiwal
Designation: Ph.D Student
Brief Background :
I am Vaibhav Madiwal, I belongs to Kolhapur city in Maharashtra. I have completed my B.Sc. in Industrial Microbiology and M.Sc. in and Microbiology from Shivaji University, Kolhapur. After completion of my post-graduation.
I joined Lupin Pharmaceuticals in fermentation department. I worked there for 2.5 years and resigned. After this I prepared for NET/SET examinations and qualified both the exam in 2016. Then I joined the Agharkar Research Institute for PhD under the guidance of Dr. K. M. Paknikar and Dr. J. M. Rajwade at Nanobioscience group.
opic of my Ph.D is nanoscale surface modification of dental materials for preventing implant related failure.
Contact Details :
Educational Qualification
- M. Sc. Microbiology, 2012, Shivaji University, Kolhapur
- CSIR-NET
- MH-SET
Research Interests
Dental implants have proven to be the best treatment policy available for the replacement lost teeth.It restores patient’s masticatory activity, phonation property, face shape and self-confidence. Dental implants have high success rate (95 %) but rate of implant failure in patient with compromised health conditions increases drastically.
Bacterial contamination of implant impedes the osseointegration process which results in increased rate of implant failure and poses heavy economical, physical, social burden on the patient. Therefore, modern dental implantology research focus on designing of implants with antibacterial and osseointegrative properties. We are working on nanoscale surface modification of dental implants using sputter deposition technology. The modified implants are tested for antibacterial activity against the oral pathogens responsible for causing peri-implantitis.
I am also studying the effect of modified implants on the expression of osteogenic marker genes. Such modified implants would further improve the rate of implant success in normal as well as compromised health conditions.
List of Publications/ Patents/Varieties
Nil
Name: Rajesh Salve
Designation: Ph.D Student
Brief Background :
I am from Jalna district, Maharashtra. I completed graduation and post-graduation in biotechnology from Dr. Babasaheb Ambedkar Marathwada University, Aurangabad. After award of NET-JRF fellowship I joined to Dr. Virendra gajbhiye for pursuing Ph. D. at nanobioscience group, Agharkar research institute.
Contact Details :
Educational Qualification
Research Interests
I am highly interested in the study of nanocarriers based targeted delivery of siRNA and anti-cancer drugs for treatment of various types of cancers like ovarian, breast, prostate etc. My main goal is to pass hurdles in cancer drug delivery and to make promising anticancer tools with nanocarrier based systems.
List of Publications/ Patents/Varieties
Name: Deepali Choudhary
Designation: PhD Student (UGC-JRF)
Brief Background :
I completed my Bachelor’s and Master’s degree in Biotechnology from Lachoo Memorial College of Science and Technology affiliated with Jai Narain Vyas University, Jodhpur. After that I did my internship from CSIR- National Chemical Laboratory Pune under the guidance of Dr. C.K John.
I have qualified CSIR-UGC junior research fellow (Dec 2018) in life science. I am currently pursuing my Ph.D. in Biotechnology at Agharkar Research Institute, Pune, Maharashtra, as a Juniour research fellow (UGC) under the guidance of Dr. Vandana Ghormade.
Contact Details :
Educational Qualification
Research Interests
RNA interference, Nanotechnology, Plant tissue culture, Plant protection. Currently we are working on nanoparticle mediated gene silencing in lepidopteran which are destroying the economically important crops.
Publications / Patents / Varieties
Name: Devyani Sengar
Designation: Ph.D. scholar (DST INSPIRE – JRF)
Brief Background :
I have completed my Bachelor’s in Life Science from Ramjas College, Delhi University, and my Master’s in Biotechnology from Annamalai University, Tamil Nadu. I worked as a research trainee in CRI Lab ACTREC, Mumbai, under the guidance of Dr. Ujjwala Warawdekar on the role of cell communication proteins and ECM proteins and their efficacy in cancer therapy. Currently, I am pursuing my Ph.D. in Biotechnology under the guidance of Dr. Virendra Gajbhiye at Nanobioscience Group, Agharkar Research Institute, Pune.
Contact Details :
Educational Qualification
Research Interests
siRNA based gene silencing, nanotechnology, nanotechnology and cancer biology. Currently, we are working on multilayered and multifunctional nanoparticle mediated siRNA delivery for gene silencing in cancer.
Publications / Patents / Varieties
Name: Surajit Patra
Designation: Ph.D. Scholar(JRF)
Brief Background :
I have completed my Bachelor’s in Zoology from Burdwan University, and my Master’s in Biotechnology from ADAMAS University, Kolkata. I worked as a research assistant at ADAMAS University in Molecular Biology and Bioinformatics. Currently, I am pursuing my Ph.D. in Biotechnology under the guidance of Dr. Virendra Gajbhiye and Dr. Yogesh Arvind Karpe at Nanobioscience Group, Agharkar Research Institute, Pune.
Contact Details :
Educational Qualification
Research Interests
Nanoparticle based recombinant vaccine development, cancer biology, virology, molecular biology, and computational biology.
Expertise in nanotechnology,
bioinformatics, molecular biology, RDT, cloning, animal cell culture, viral culture, bacterial culture, PCR, protein purification, SDS-PAGE, western blotting,
FACS, animal handling, ELISA.
List of Publications/ Patents/Varieties
Name: Rajkumar Samanta
Designation: Ph.D. Scholar (DBT-JRF)
Brief Background :
I have completed my graduation in Zoology, 2019 from Midnapore collegeCollege, Vidyasagar University, West Bengal. I have completed my masters in 2021 in biotechnology from Utkal University, Odisha. Currently doing Ph.D. in Biotechnology under the Guidance of Dr. Virendra Gajbhiye in the nanobioscience group of ARI.
Contact Details :
Educational Qualification
Research Interests
CRISPR/Cas9 system,nanotechnology and cancer biology. Currently we are working on nanoparticle mediated CRISPR/Cas9 system delivery in cancer cells for checking gene editing efficiency of CRISPR/Cas system.
List of Publications/ Patents/Varieties
Name: Niladri Haldar
Designation: DBT-JRF (Ph.D. Student)
Brief Background :
I have done my Bachelor’s (Zoology) from University of Calcutta, Kolkata and Master’s (Biotechnology) from Utkal University, Bhubaneswar. I have qualified CSIR-JRF in June, 2019 and DBT-JRF in 2020. Presently, I am pursuing Ph.D. (Biotechnology) under the supervision of Dr. Virendra Gajbhiye at ARI, Pune.
Contact Details :
Educational Qualification
Research Interests
Gene editing and gene silencing technology, Nano-based delivery systems, Cancer biology.
Currently, I am focusing on the development of a lipid-based
nanocarrier for the delivery of CRISPR-Cas9 system in cancer cells. I am also working on siRNA-mediated gene silencing in cancer cells using a
silica-based nanocarrier.
List of Publications/ Patents/Varieties
Name: Kajal Pardhi
Designation: Ph.D. Students (UGC-JRF)
Brief Background :
I completed my postgraduate studies in biotechnology at Dr. Ambedkar College in Nagpur, affiliated with Rashtrasant Tukadoji Maharaj Nagpur University (RTMNU). My undergraduate studies in biotechnology, microbiology, and chemistry were completed at Dhote Bandhu Science College in Gondia. I am eligible to compete in the UGC-JRF and GATE-BT examinations in February 2022. Currently, I am pursuing a Ph.D. in biotechnology under the guidance of my advisor, Dr. Monali C. Rahalkar.
Contact Details :
Educational Qualification
Research Interests
My research focuses on the isolation and cultivation of methanotrophic bacteria from wetland environments for the applications in carotenoid production and use as methane mitigation agents. Through molecular identification techniques, I aim to characterize these bacteria and their unique metabolic capabilities.
List of Publications/ Patents/Varieties
Name: Shubha Satish Manvi
Designation: Ph.D. Student
Brief Background :
With deep interest in core microbiology, I have completed my Masters in Applied Microbiology from VIT University, Vellore and Bachelors in Microbiology from Fergusson College, Pune.
After completing my degree, I have worked in the field of nanocapsule making, plant tissue culture and anaerobic mycology.
Contact Details :
Educational Qualification
- B.Sc in Microbiology (2011-2014) from Fergusson College, Pune.
- M.Sc in Applied Microbiology (2014-2016) from VIT University, Vellore
Research Interests
I am currently working on employing methanotrophs, the only known methane biofilters for oxidizing the methane emitted in wetlands and rice fields. Rice fields account for a major source of anthropogenic methane emissions owing to the activity of methanogens in the anoxic layers of soils. By the methane oxidizing activity of methanotrophs, the methane released in the atmosphere can be regulated, thus reducing the GHG emissions, and aiding in plant growth promotion of rice plants. The use of methanotrophs in agriculture reduces the dependency on chemical fertilizers like urea as well.
List of Publications/ Patents/Varieties
- Shubha Manvi, Varsha Parasharami, ‘Garcinia indica Choisy: Screening of location for donor female mother plants for micropropagation with effective protocol for establishment of sterile and healthy cultures’, Acta Scientific Agricultural Journal, Vol. 5(7), July 2019 https://actascientific.com/ASAG/pdf/ASAG-03-0514.pdf
- Gauri Mulik, Shubha Manvi, Gauri Ingale, Dr. Varsha Parasharami, Optimization of IBA for efficient rooting in micropropagated Garcinia indica Choisy for in-vitro and ex-vitro studies, Asian Journal Plant Reseasrch, Vol 2(4), May 2019 http://www.journalaprj.com/index.php/APRJ/article/view/30050/56390
- Shubha Manvi, Ushashi Bhattacharya, Veena Sreedharan, Dr. Bhaskar Rao K.V., Antimicrobial Activity of Streptococus variabilis strain- VITUMVB03 isolated from Kanyakunari marine sediments, Asian Journal of Pharmaceutical and clinical Research, Vol. 10 (9), September 2017 https://innovareacademics.in/journals/index.php/ajpcr/article/view/19250/12246
Name: Jyoti Arun Mohite
Designation: Ph.D. Scholar
Brief Background :
I was working as assistant professor in Microbiology Department at Modern College Shivajinagar, Pune. I have joined MACS-Agharkar research institute, Pune as a research student and registered for Ph.D.
Contact Details :
Educational Qualification
- B.Sc Biotechnology – Shivaji University 2013
- M.Sc Microbiology- SPPU 2015
Research Interests
Methanotroph biology and itsapplications, Microbial diversity and ecology.
List of Publications/ Patents/Varieties
- Khatri, K., Mohite, J.A., Pandit, P.S., Bahulikar, R. and Rahalkar, M.C., 2019. Description of ‘Ca. Methylobacter oryzae’KRF1, a novel species from the environmentally important Methylobacter clade 2. Antonie van Leeuwenhoek, pp.1-7.
https://doi.org/10.1007/s10482-019-01369-2 - Khatri, K., Pandit, P. S., Mohite, J. A., Bahulikar, R. A., & Rahalkar, M. C. (2019). A novel gammaproteobacterial methanotroph from Methylococccaeae; strain FWC3, isolated from canal sediment from Western India. BioRxiv, 696807. https://doi.org/10.1101/696807
- Rahalkar, M., Khatri, K., Mohite, J., Pandit, P., &Bahulikar, R. (2020). Description and Genome Analysis of Methylotetracoccus aquaticus sp. nov., a Novel Tropical Wetland Methanotroph, with the Amended Description of Methylotetracoccus gen. nov.https://doi.org/10.20944/preprints202001.0173.v1
- Rahalkar, M. C., Khatri, K., Mohite, J., Pandit, P. S., &Bahulikar, R. A. (2020). A novel Type I methanotroph Methylolobus aquaticus gen. nov. sp. nov. isolated from a tropical wetland. Antonie van Leeuwenhoek, 1-13. https://doi.org/10.1007/s10482-020-01410-9
Name: Shirish Satish Kadam
Designation: Project Assistant - II
Brief Background :
I pursued my M. Sc degree in Biotechnology from Rajarshri Shahu Mahavidyalaya and completed my six-month project training program at MACS Agharkar Research Institute under Dr.Rahalkar. The world of methanotrophs fascinated me for their ability to oxidize methane and thus reduce global warming. In my six-month training program, we successfully explored the potential of methanotrophs to promote plant growth of rice crops and increase yield.
To further continue my research, I joined as a project assistant under the expert guidance of Dr. Monali C. Rahalkar to work on the cultivation and maintenance of methanotroph cultures for application in rice crop PGPR and methane oxidation potential.